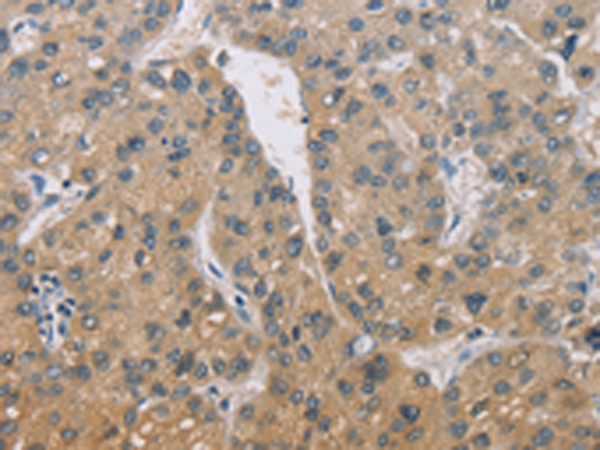
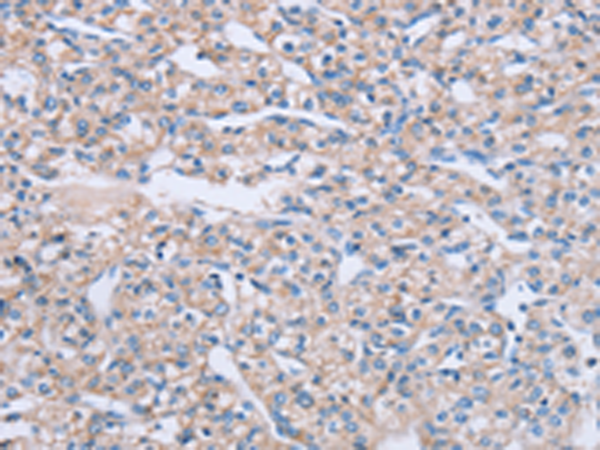

-
分类: 科研抗体货号: P03683别名: ZID; ZNF482应用: IHC反应种属: Human, Mouse
-
分类: 科研抗体货号: P03750别名: RAB6应用: WB,IHC反应种属: Human, Mouse, Rat
-
分类: 科研抗体货号: P03711别名: MRX; MXR; ABCP; BCRP; BMDP; MXR1; ABC15; BCRP1; CD338; GOUT1; MXR-1; CDw338; UAQTL1; EST157481应用: WB,IHC反应种属: Human
-
分类: 科研抗体货号: P03747别名: UBXD4应用: WB反应种属: Human, Mouse
-
分类: 科研抗体货号: P03761别名: ADMP-2; ADAM-TS5; ADAMTS-5; ADAMTS11; ADAM-TS 5; ADAMTS-11; ADAM-TS 11应用: WB,IHC反应种属: Human, Mouse
-
分类: 科研抗体货号: P03710别名: TAPL, EST122234应用: WB,IHC反应种属: Human
-
分类: 科研抗体货号: P03743别名: NGFB; HSAN5; Beta-NGF应用: WB,IHC反应种属: Human, Mouse, Rat
-
分类: 科研抗体货号: P03757别名: TFQTL1; PRO1557; PRO2086应用: WB,IHC反应种属: Human
-
分类: 科研抗体货号: P03792别名: NS7; B-raf; BRAF1; RAFB1; B-RAF1应用: WB,IHC反应种属: Human, Mouse
-
分类: 科研抗体货号: P03742别名: GOV; D2-2; RAB16; RAD3D应用: IHC反应种属: Human, Mouse, Rat

鄂公网安备42018502007531号
鄂公网安备42018502007531号

